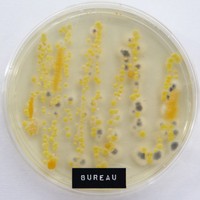

Maak je persoonlijk werkkompas
Een persoonlijk werkkompas is effectief en doeltreffend wanneer je je functie en taken als managementondersteuner wilt beschouwen. Zo kun je toetsen of dat wat je doet nog bij jou past en of het binnen je werkcarrièreperspectief valt. Maar het is ook handig in tijden van functioneringsgesprekken, bila's, een gewenste promotie of een nieuwe baan! Jocelyn Rebbens gaat hier uitgebreid op in tijdens de workshop <a href="http://www.mansupportworkshops.nl/workshops/workshops/persoonlijke-ontwikkeling/relevant-blijven-voor-je-organisatie-en-jezelf?v=02241115" target="_blank">Relevant blijven voor je organisatie en jezelf</a> en licht hier alvast het kompas toe.